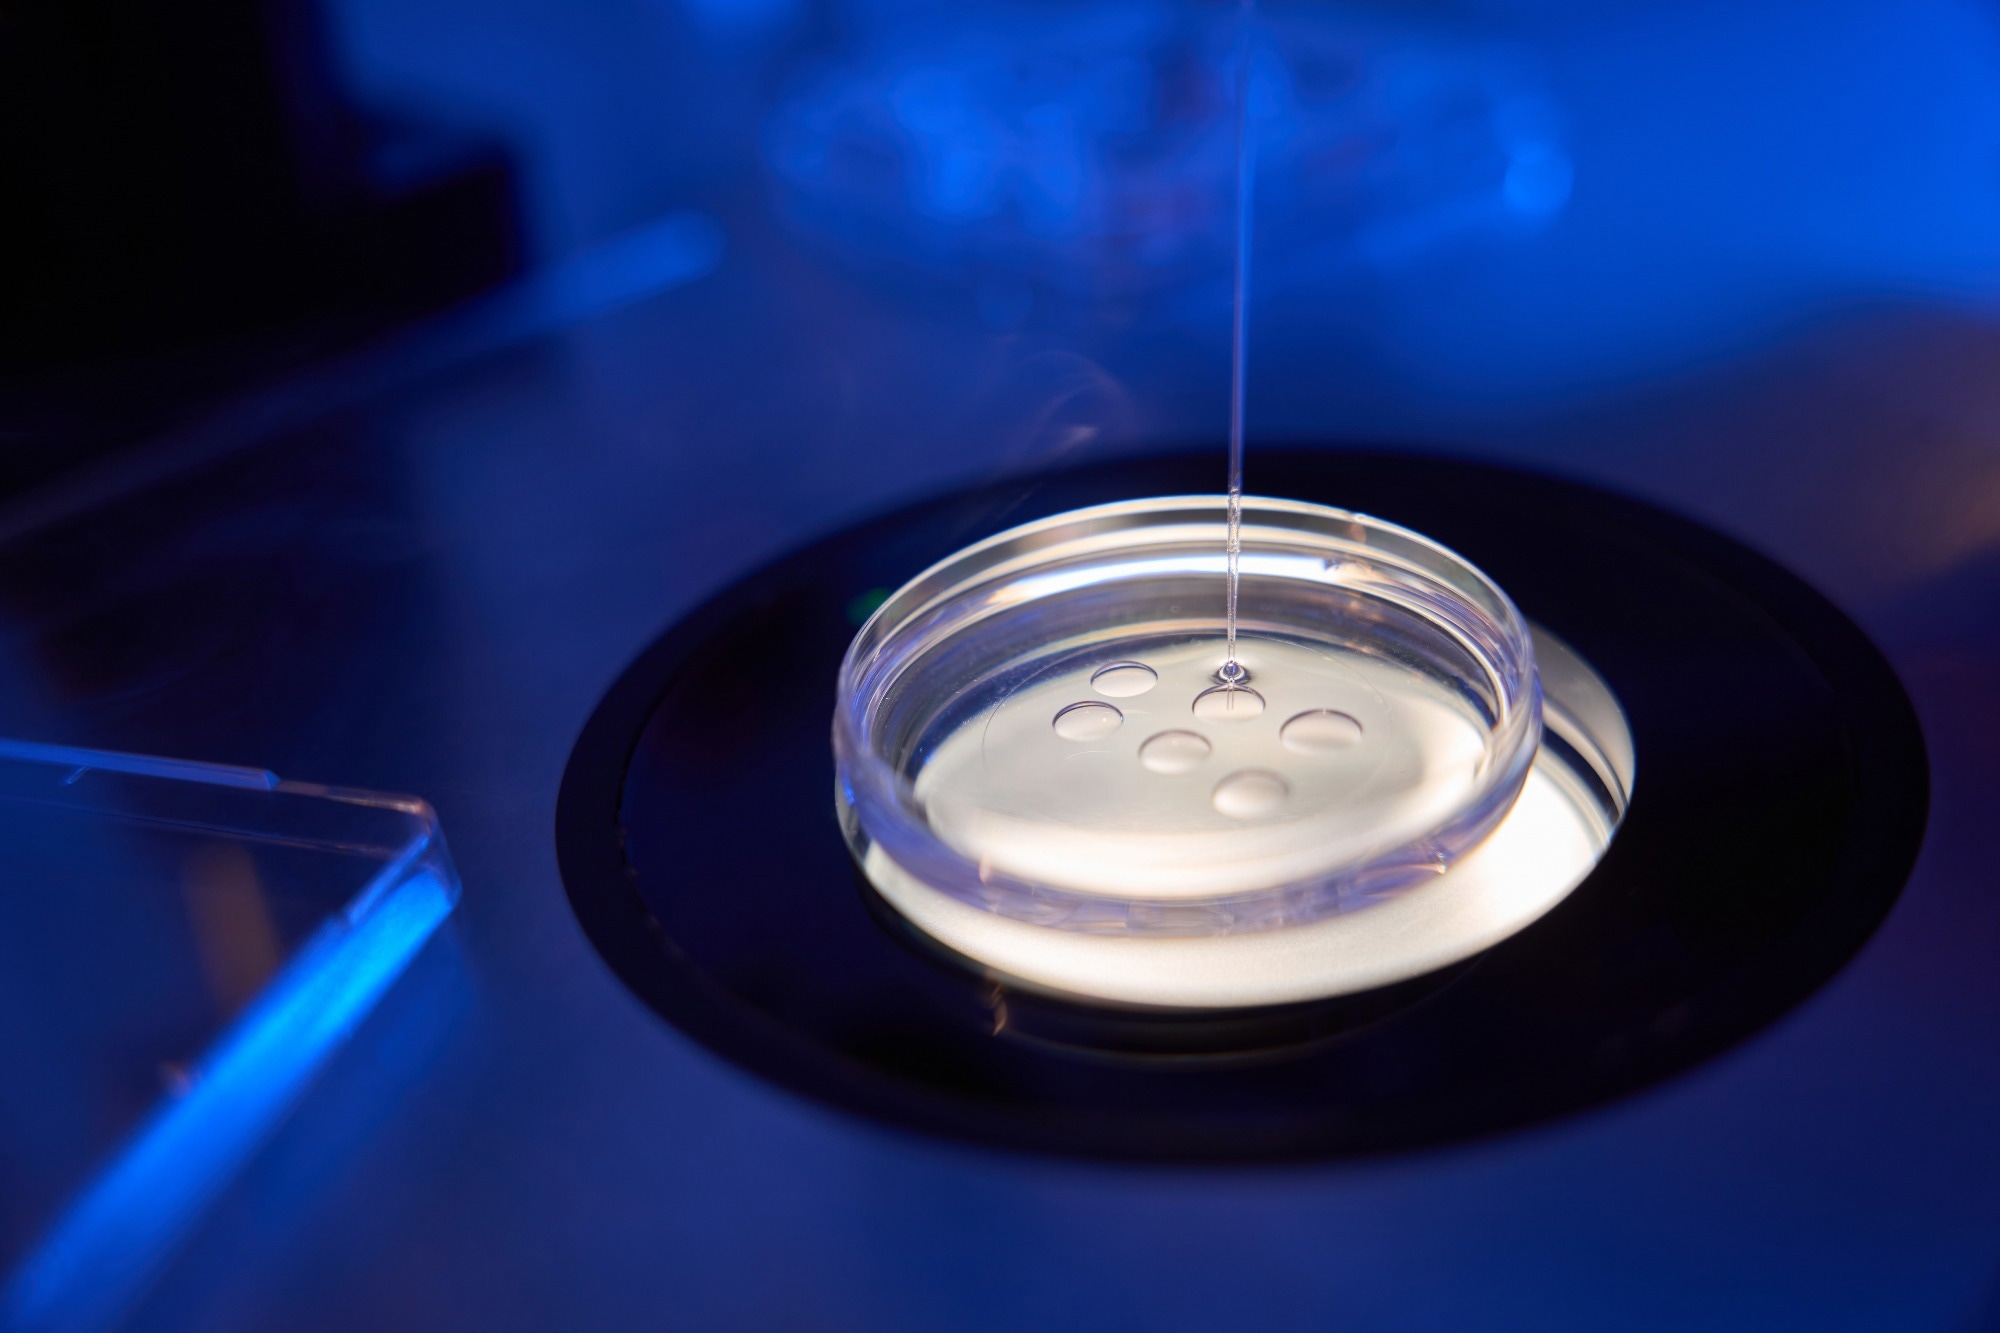

The acquiring of oocyte developmental competence is a key process that results in enabling an oocyte to be fertilized and sustain the early stages of embryonic development.1,2 Abnormalities that arise throughout the folliculogenesis results in infertility and can lead to multiple failures with assisted reproductive technologies (ART) such as in vitro fertilization (IVF) and intracytoplasmic sperm injection (ICSI).1,3
Image Credit: Svitlana Hulko/Shutterstock.com
Image Credit: Svitlana Hulko/Shutterstock.com
The World Health Organization has estimated that infertility impacts one in six couples.4 Regardless of the recent progress that has been achieved with ARTs, infertility treatment is still considered suboptimal, with a rate of pregnancy per retrieved oocyte during IVF of just 4.5 %.5 Improving comprehension of the processes leading to the formation of a high-quality oocyte would lead to improvements in ART.5
One characteristic of oocyte development and physiology that has been a mystery for 60 years is the highly present cytoplasmic lattices within the cytoplasm of mammalian oocytes. These were initially seen through electron microscopy in the 1960s, but scientists failed to agree on their function.3 In recent years, they were believed to be structures that stored chains of ribosomes, similar to a string of beads.2,3,6
Several oocyte-specific proteins have been categorized as crucial to forming cytoplasmic lattices, particularly PADI6 (peptidylarginine deaminase) and the SCMC (subcortical maternal complex). In humans and mice, gene mutations of these proteins lead to arrested embryonic development.3
Researchers at the Max Planck Institute for Multidisciplinary Sciences in Göttingen, Germany, have studied the cytoplasmic lattice's function and structure and the relationship to PADI6 and SCMC.3
Discovering the 3D organization of cytoplasmic lattices
The researchers began exploring the localization of PADI6 and SCMC proteins within oocytes.
Using HaloTag labeling technique and super-resolution microscopy, they discovered that PADI6 and SCMC proteins are spread throughout the cytoplasm during different stages of meiosis and early embryo development.3
Further analysis were focused on the 3-dimensional structure of PADI6 and SCMC demonstrating that the proteins were thickly packed into fibers that measured around 100 nm wide and, on average, 700 nm long. These fibers were the cytoplasmic lattice, which illustrated that cytoplasmic lattices are, by definition, fibers dense in PADI6 and SCMC.3
To discover the 3D organization of cytoplasmic lattices, researchers employed room-temperature electron tomography (RT-ET), while cryo-electron tomography (cryo-ET) enables the visualization of cellular complexes in situ.
In the RT-ET samples of mouse oocytes, researchers identified individual filaments within the lattice fibers, noting their helical arrangement. Statistical analysis revealed that the filaments are approximately 200 nm long. An average of 22 filaments was identified within a fiber-cross section.
Cryo-ET further confirmed the helical nature of these fibers, showing multiple stacked filaments. Persistence length analysis indicated that the stiffness of these filaments is similar to that of amyloid fibrils and microtubules, highlighting their structural robustness. Overall, the study provides an in-depth look at the organization and mechanical properties of cytoplasmic lattice filaments.
The assembly of the cytoplasmic lattice requires PADI6 and SCMC proteins, which may serve as fundamental elements of the filaments.
A protein storage structure
The study, published in Cell, indicates that cytoplasmic lattices store proteins crucial for embryonic development. The authors explain that these proteins are a stockpile that allows the egg to provide the embryo with its requirements in the initial stages.
The compartmentalization of the proteins to the lattice may also be purposeful, for example, the prevention of proteins accessing the nucleus or mitochondria or arranging them into complexes like ribosomes. It may also offer protection from degradation, enabling further protein accumulation.3
The researchers have said that a greater appreciation of the part played by PADI6 and SCMC proteins could prevent women with mutations in cytoplasmic lattice genes from undergoing the emotional and financial burden of repeated failed rounds of ART. This knowledge could result in new therapies that aid normal embryo development, even with these mutations.3
Thermo Fisher technology
For this study, the team used the XTracing module in Thermo Fisher Amira software to automate the detection and 3D visualization of the cytoplasmic lattices.
Amira is a powerful 3D platform that offers advanced image processing, analysis, and visualization tools. The software offers great customization, enabling adaptation to your 3D visualization needs.
In addition to XTracing, Amira offers software extensions for molecular visualization and large data management. It also enables you to create custom components using the C++ programming language.
References and further reading
- Innocenti F, Fiorentino G, Cimadomo D, et al. Maternal effect factors that contribute to oocytes developmental competence: an update. J Assist Reprod Genet. 2022;39(4):861-871. DOI: 10.1007/s10815-022-02434-y
- Longo M, Boiani M, Redi C, et al. Cytoplasmic lattices are not linked to mouse 2-cell embryos developmental arrest. Eur J Histochem. 2018;62(4):2972. DOI: 10.4081/ejh.2018.2972
- Jentoft IMA, Bäuerlein FJB, Welp LM, et al. Mammalian oocytes store proteins for the early embryo on cytoplasmic lattices. Cell. 2023;186(24):5308-5327.e25. DOI: 10.1016/j.cell.2023.10.003
- World Health Organization (2023). Infertility Prevalence Estimates, 1990–2021 Available at: https://www.who.int/publications/i/item/978920068315. Accessed June 2024.
- Conti M, Franciosi F. Acquisition of oocyte competence to develop as an embryo: integrated nuclear and cytoplasmic events. Hum Reprod Update. 2018;24(3):245-266. DOI: 10.1093/humupd/dmx040
- Yurttas P, Vitale AM, Fitzhenry RJ, et al. Role for PADI6 and the cytoplasmic lattices in ribosomal storage in oocytes and translational control in the early mouse embryo. Development. 2008;135(15):2627-36. DOI: 10.1242/dev.016329

Sponsored Content Policy: News-Medical.net publishes articles and related content that may be derived from sources where we have existing commercial relationships, provided such content adds value to the core editorial ethos of News-Medical.Net which is to educate and inform site visitors interested in medical research, science, medical devices and treatments.